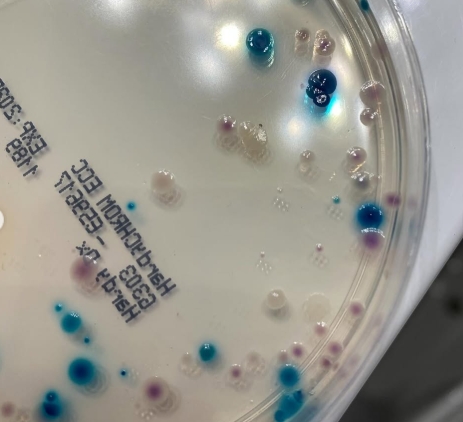

What is the SCCW project?
Our student-led non-profit 501(c)(3) focuses on ensuring balanced water quality in North Carolina for recreation, consumption, and the overall well-being of the watershed.

Database
After building a statistically significant library of water quality data, our students have organized those findings into a publicly accessible archive with the help of experienced database specialists.

Action
Using those findings, our students collaborate with recognized public policy, business and water quality experts to develop legislative recommendations to ensure that North Carolina’s watersheds are optimally managed.

Partnership
We will partner with municipal water departments and environmental NGOs to train and equip high school volunteers to perform a variety of water quality tests on the watershed areas around their residences.

Impact
We seek to educate young leaders in STEM skill fluency, environmental awareness, understanding the legislative process, and fostering positive change. Our students have met with elected officials to propose updated legislation aimed at improving the existing legal framework.
View Our Findings
View our interactive database to see our outreach within the Charlotte area.

Our greatest goal is to build scientific skills and a balanced awareness of environmental issues. A secondary goal is to propose new legislation based on our findings to political bodies, including the North Carolina legislature.
Our Mission

Donate to Support
You can help us make an impact with a donation of any size.

